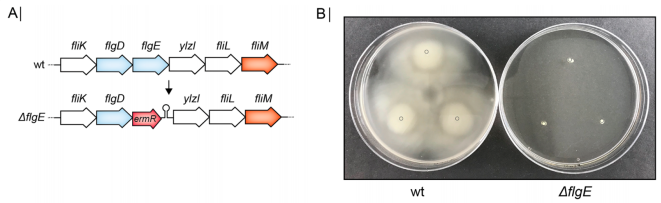
172550202230343273.png image.png

由P4199启动子驱动的JE1zyn合成基因,通过SOE PCR与氯霉素抗性标记融合,并通过同源重组整合到PEL基因座,产生TKK0007。与大观霉素抗性标记融合的Te Cas9d盒被整合到AmyE基因座,产生TKK0016。通过SOE-PCR将pE194的Erm基因(包括其天然终止子)与fgE的上下游扇形区融合,进行fgE敲除。将Te SOE片段转化到TKK0007中,从1µg/mL ERM LB板中选择转化体,所得菌株为BT11018。

参考文献:Fehler AO, Kallehauge TB, Geissler AS, González-Tortuero E, Seemann SE, Gorodkin J, Vinther J. Flagella disruption in Bacillus subtilis increases amylase production yield. Microb Cell Fact. 2022 Jul 2;21(1):131.
由P4199启动子驱动的JE1zyn合成基因,通过SOE PCR与氯霉素抗性标记融合,并通过同源重组整合到PEL基因座,产生TKK0007。与大观霉素抗性标记融合的Te Cas9d盒被整合到AmyE基因座,产生TKK0016。通过SOE-PCR将pE194的Erm基因(包括其天然终止子)与fgE的上下游扇形区融合,进行fgE敲除。将Te SOE片段转化到TKK0007中,从1µg/mL ERM LB板中选择转化体,所得菌株为BT11018。
参考文献:Fehler AO, Kallehauge TB, Geissler AS, González-Tortuero E, Seemann SE, Gorodkin J, Vinther J. Flagella disruption in Bacillus subtilis increases amylase production yield. Microb Cell Fact. 2022 Jul 2;21(1):131.